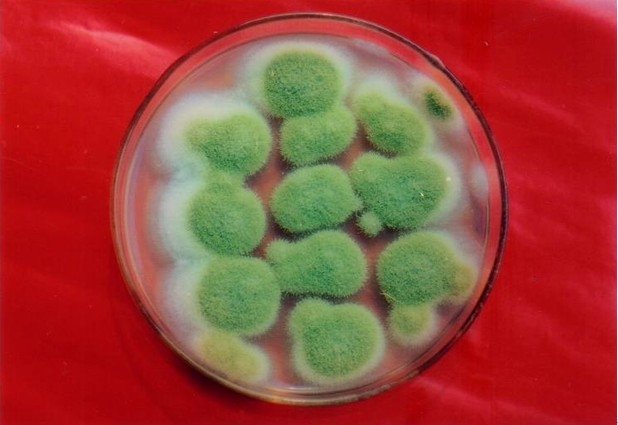
米曲霉

米曲霉孢子

米曲霉
图片尺寸300x225
好好好,又离成功远了一步#毛霉#发疯日常 #实验 #米曲霉 - 抖音
图片尺寸1440x1920
形态特征米曲霉有球形或近球形的分生孢子(简称孢子),黄绿色,孢子直径
图片尺寸543x405
米曲霉是一种丝状真菌,或霉菌,用于食品生产,如在大豆发酵教育实验室.
图片尺寸1200x800
米曲霉是一种丝状真菌,或霉菌,用于食品生产,如在大豆发酵教育实验室.
图片尺寸1200x800
米曲霉
图片尺寸618x425
成熟米曲霉
图片尺寸3264x2448
米曲霉
图片尺寸550x522
米曲霉是一种丝状真菌或霉菌,用于食品生产,如在实验室显微镜下大豆
图片尺寸1200x800
曲霉的有性孢子 曲霉的孢子是什么形状?-图片大观-奇异网
图片尺寸634x1130
米曲霉菌株及其应用,米曲霉制剂
图片尺寸1595x809
米曲霉是一种丝状真菌,或霉菌,用于食品生产,如在大豆发酵教育实验室.
图片尺寸1200x800
米曲霉是一种丝状真菌,或霉菌,用于食品生产,如在大豆发酵教育实验室.
图片尺寸1200x800
米曲霉菌株及其应用,米曲霉制剂_cn201911400210.9_知雀网
图片尺寸1000x507
米曲霉是一种丝状真菌或霉菌,用于食品生产,如在实验室显微镜下大豆
图片尺寸1200x800
米曲霉的介绍
图片尺寸554x365
米曲霉米曲霉米曲霉米曲霉米曲霉青霉 penicillium青霉能产生青霉素
图片尺寸1280x960
一株用于黄酒制曲的高糖化力迟产孢子的米曲霉及应用
图片尺寸1483x712
米曲霉-检验图谱
图片尺寸448x336
一株米曲霉za160及其应用的制作方法
图片尺寸986x1000